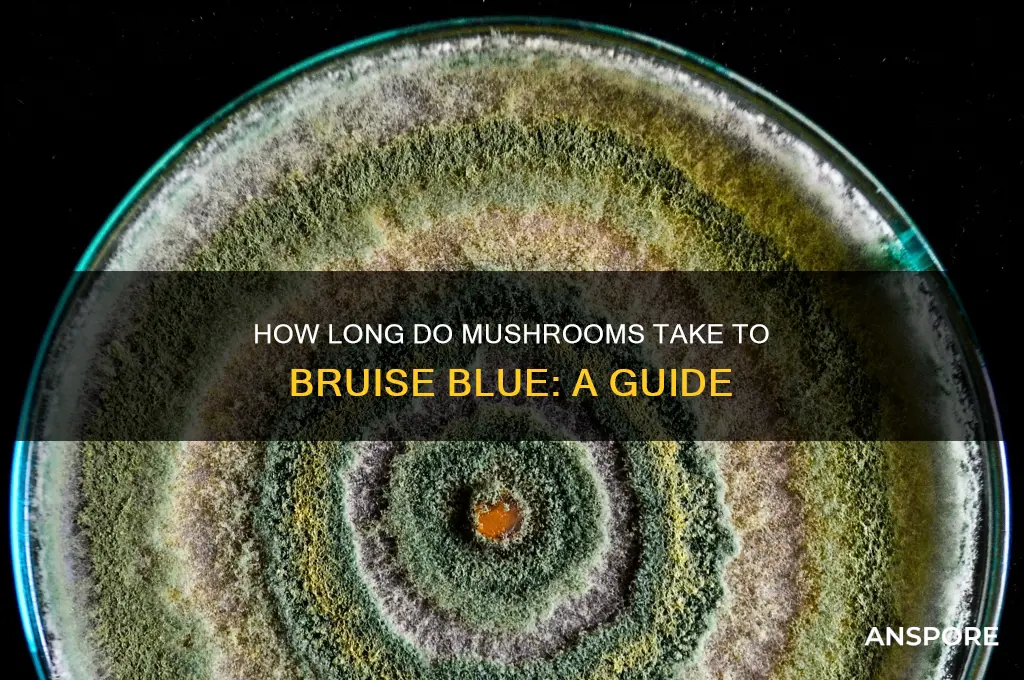
how long do mushrooms take to bruis blue

When exploring the fascinating world of mushrooms, particularly those that bruise blue, one common question arises: how long does it take for them to develop this distinctive coloration? The blue bruising is typically a result of psilocin and psilocybin oxidizing when the mushroom tissue is damaged, a process that can occur within minutes to hours after the mushroom is picked or handled. Factors such as the species, freshness, and environmental conditions can influence the speed and intensity of the bruising. For example, *Psilocybe cubensis* often bruises blue almost immediately upon contact, while other species may take longer. Understanding this timeline is crucial for foragers and enthusiasts to identify and handle these mushrooms properly, ensuring both safety and accurate species recognition.
| Characteristics | Values |
|---|---|
| Mushroom Species | Primarily Psilocybe species (e.g., Psilocybe cubensis, Psilocybe cyanescens) |
| Bruising Color | Blue, green, or purple |
| Time to Bruise | 15 minutes to 2 hours after physical damage or handling |
| Cause of Bruising | Oxidation of psilocin (a psychedelic compound) upon exposure to air |
| Permanence of Bruise | Temporary; color may fade over time |
| Significance of Bruising | Indicates presence of psychoactive compounds (psilocybin/psilocin) |
| Environmental Factors | Temperature, humidity, and freshness of mushrooms can affect bruising speed |
| Comparison to Non-Psychoactive Mushrooms | Most non-psilocybin mushrooms do not bruise blue |
| Preservation of Color | Drying or cooking may alter or remove the blue bruising |
| Safety Note | Bruising is a natural process and does not indicate spoilage |
Explore related products
What You'll Learn
- Factors affecting bruising time (humidity, mushroom age, species, handling, storage conditions, pressure applied)
- Common blue-bruising species (Psilocybe cubensis, Panaeolus cyanescens, Gymnopilus species, rapid vs. slow bruisers)
- Bruising speed indicators (immediate, gradual, delayed, or no bruising, color intensity changes)
- Impact of bruising on potency (psilocybin degradation, safe consumption, potency loss, visual vs. chemical changes)
- Preventing or accelerating bruising (gentle handling, drying methods, environmental control, intentional pressure application)

Factors affecting bruising time (humidity, mushroom age, species, handling, storage conditions, pressure applied)
Factors Affecting Bruising Time in Mushrooms
Humidity plays a significant role in how quickly mushrooms bruise blue. Higher humidity levels can accelerate the bruising process because moisture on the mushroom's surface interacts with the psilocybin compounds, causing them to oxidize faster. In dry conditions, mushrooms may take longer to bruise as the lack of moisture slows down the chemical reaction. For example, mushrooms stored in a humid environment (above 80% relative humidity) may show visible bruising within minutes, while those in drier conditions (below 50% humidity) could take several hours. Maintaining optimal humidity levels during storage and handling is crucial for controlling bruising time.
Mushroom age is another critical factor. Younger mushrooms tend to bruise more quickly than older ones due to their higher water content and more active enzymatic processes. As mushrooms age, their cell walls become tougher, and their moisture content decreases, making them less prone to immediate bruising. Freshly harvested mushrooms might bruise within seconds to minutes when handled, while older mushrooms could take up to an hour or more to show discoloration. Therefore, the age of the mushroom at the time of handling or storage directly influences how rapidly it will bruise blue.
Species of mushrooms also significantly impact bruising time. Psilocybe cubensis, for instance, is known to bruise blue almost instantly when damaged, while other species like Psilocybe cyanescens may take slightly longer due to differences in their psilocybin content and cell structure. Some species may not bruise blue at all, as the chemical composition varies widely among mushrooms. Understanding the specific characteristics of the species being handled is essential for predicting and managing bruising time effectively.
Handling practices can either expedite or delay bruising. Rough handling, such as squeezing or dropping mushrooms, applies pressure that immediately damages cell walls, leading to rapid bruising. Gentle handling, on the other hand, minimizes cell damage and slows down the bruising process. Additionally, the use of tools or gloves during handling can reduce direct contact and pressure, further delaying bruising. Proper training in handling techniques is vital to maintain the integrity of mushrooms and control bruising time.
Storage conditions are pivotal in determining how long mushrooms take to bruise blue. Mushrooms stored in cool, dark, and dry conditions with minimal physical contact will bruise more slowly compared to those stored in warm, humid environments where they are frequently moved or stacked. Proper ventilation and the use of non-reactive containers can also help reduce bruising. For long-term storage, maintaining a consistent temperature (around 2-4°C) and low humidity can significantly slow down the bruising process, preserving the mushrooms' appearance and potency.
Pressure applied during handling or storage directly correlates with bruising time. Even slight pressure, such as stacking mushrooms or placing heavy objects on them, can cause cell damage and lead to bruising. The greater the pressure, the faster the bruising occurs. For example, mushrooms compressed in a tight container may bruise within minutes, while those stored loosely with minimal pressure could take hours. Being mindful of how much pressure is exerted on mushrooms during every stage of handling and storage is essential for minimizing unwanted bruising.
Perfectly Cooked Shimeji Mushrooms: Timing Tips for Delicious Results
You may want to see also

Common blue-bruising species (Psilocybe cubensis, Panaeolus cyanescens, Gymnopilus species, rapid vs. slow bruisers)
When exploring the topic of how long mushrooms take to bruise blue, it's essential to focus on common blue-bruising species, which include Psilocybe cubensis, Panaeolus cyanescens, and Gymnopilus species. These mushrooms are known for their distinctive blue bruising reaction when their tissues are damaged, a result of the oxidation of psilocin, a psychoactive compound. Understanding the bruising speed and characteristics of these species is crucial for identification and cultivation.
Psilocybe cubensis is one of the most well-known blue-bruising mushrooms, widely cultivated for its psychoactive properties. When damaged, its flesh typically begins to turn blue within 15 to 30 minutes, with the color intensifying over the next few hours. This rapid bruising is a key identifier for foragers and cultivators alike. The blue hue is more pronounced in fresher specimens and may fade slightly over time. P. cubensis is a "rapid bruiser," making it relatively easy to distinguish from other species that may take longer to exhibit this reaction.
Panaeolus cyanescens, another common blue-bruising species, is known for its potent psychoactive effects and distinct appearance. Unlike P. cubensis, P. cyanescens often bruises more quickly, with the blue color appearing within 5 to 10 minutes of tissue damage. This species is considered an "ultra-rapid bruiser," and its intense reaction is a reliable field identification marker. However, its smaller size and different habitat preferences (often found in grassy areas) differentiate it from P. cubensis.
Gymnopilus species, while less commonly associated with psychoactive properties, also exhibit blue bruising due to the presence of psilocin or related compounds. These mushrooms typically bruise more slowly compared to P. cubensis and P. cyanescens, with the blue color taking 30 minutes to several hours to develop fully. Gymnopilus species are "slow bruisers," and their reaction is often less uniform, with the color appearing in patches rather than uniformly across the damaged area. This slower bruising can make identification more challenging, especially for inexperienced foragers.
The distinction between rapid and slow bruisers is critical for accurate identification and safe foraging. Rapid bruisers like P. cubensis and P. cyanescens provide immediate visual confirmation of their presence, while slow bruisers like Gymnopilus species require patience and careful observation. Additionally, the intensity and uniformity of the blue bruising can vary based on factors such as the mushroom's age, environmental conditions, and the extent of tissue damage. Foragers should always cross-reference bruising reactions with other identifying features, such as spore color, habitat, and macroscopic characteristics, to ensure accurate identification.
In summary, understanding the bruising speed of common blue-bruising species is essential for both identification and cultivation. Psilocybe cubensis and Panaeolus cyanescens are rapid bruisers, with blue hues appearing within minutes to half an hour, while Gymnopilus species bruise more slowly, taking hours to develop color. By recognizing these differences, foragers and cultivators can more confidently identify these mushrooms and appreciate their unique characteristics. Always exercise caution and ensure proper identification before handling or consuming any wild mushrooms.
Freshness Timeline: How Long Do Mushrooms Last in the Fridge?
You may want to see also

Bruising speed indicators (immediate, gradual, delayed, or no bruising, color intensity changes)
When assessing the bruising speed of mushrooms, particularly those that turn blue, it’s essential to observe how quickly and intensely the color change occurs after handling or damage. Immediate bruising is the fastest indicator, where the mushroom tissue turns blue within seconds to a few minutes of being touched, cut, or bruised. This rapid reaction is often seen in species like *Psilocybe cubensis*, where the blueing is a clear sign of psilocybin oxidation. Immediate bruising is a critical field identification trait and typically intensifies within 10–15 minutes, making it a reliable and quick test for foragers.
Gradual bruising occurs when the blue color develops more slowly, taking anywhere from 15 minutes to a few hours. This type of bruising is less intense initially but becomes more pronounced over time. Species like *Panaeolus cyanescens* may exhibit gradual bruising, where the blueing starts faintly and deepens as the mushroom’s compounds react with oxygen. Foragers should note the progression of color change, as gradual bruising can still confirm the presence of psilocybin, though it requires more patience to observe.
Delayed bruising is characterized by a significant time lapse between the physical damage and the appearance of blueing, often taking several hours or even overnight. This is less common but can occur in certain mushroom species or under specific environmental conditions. Delayed bruising may be influenced by factors like humidity, temperature, or the mushroom’s freshness. While it is still a valid indicator, it requires careful documentation and comparison to other identification features.
No bruising is another important observation, as not all mushrooms that contain psilocybin or similar compounds will turn blue when damaged. Some species, like *Psilocybe semilanceata*, may show little to no bruising despite their psychoactive properties. In such cases, other identification methods, such as spore prints, habitat, and morphological features, become crucial. Absence of bruising does not necessarily rule out the presence of psilocybin, but it does limit the use of blueing as a quick field test.
Color intensity changes are a key aspect of bruising speed indicators. Immediate and gradual bruising often start with a faint blue or greenish hue that deepens to a darker blue or indigo over time. The intensity of the color can vary based on the concentration of psilocybin and environmental factors. Foragers should pay attention to how the color evolves, as this can provide additional clues about the mushroom’s potency and species. Documenting the initial and final color intensity can also aid in accurate identification and differentiation from non-bruising species.
Understanding these bruising speed indicators—immediate, gradual, delayed, or no bruising, along with color intensity changes—is vital for accurately identifying mushrooms that turn blue. Each pattern offers unique insights into the mushroom’s chemical composition and species, helping foragers make informed decisions in the field. Always cross-reference bruising observations with other identification methods to ensure safety and accuracy.
Mastering Mushroom Log Soaking: Optimal Time for Fruiting Success
You may want to see also
Explore related products

Impact of bruising on potency (psilocybin degradation, safe consumption, potency loss, visual vs. chemical changes)
When mushrooms bruise and turn blue, it’s a visual indicator of oxidation, specifically the enzymatic breakdown of psilocybin into psilocin and other compounds. This process is rapid, often occurring within minutes to hours after the mushroom tissue is damaged. While the blue color is a clear sign of chemical change, it does not necessarily mean the psilocybin has fully degraded. However, prolonged exposure to air, light, or heat can accelerate psilocybin degradation, leading to potency loss over time. The blue bruising itself is a visual cue that some psilocybin has already converted, but the extent of potency loss depends on factors like the mushroom species, environmental conditions, and the degree of physical damage.
From a safe consumption perspective, bruising does not render mushrooms unsafe to ingest. The blue color is a natural reaction and does not indicate toxicity. However, it does suggest that the mushroom has been exposed to conditions that may reduce its psilocybin content. Users should be aware that bruised mushrooms may have a lower potency, which could affect the intended experience. It’s also important to note that while visual changes are immediate, chemical degradation is a gradual process, meaning that even slightly bruised mushrooms may still retain significant psilocybin levels if consumed promptly.
The potency loss due to bruising varies depending on the extent of damage and storage conditions. Minor bruising, such as that caused by handling during harvesting, may result in minimal psilocybin degradation. However, severe bruising or prolonged exposure to air can lead to more significant potency loss. For example, mushrooms left in a warm, humid environment after bruising will degrade faster than those stored in a cool, dark place. Users seeking consistent potency should minimize physical damage and store mushrooms properly, though some bruising is nearly unavoidable during harvesting and preparation.
It’s crucial to distinguish between visual changes and actual chemical degradation. The blue color is a superficial indicator of oxidation but does not directly correlate to the total psilocybin content remaining in the mushroom. Chemical analysis would be required to accurately measure potency loss, as the visual bruising only reflects the conversion of surface psilocybin. Therefore, while bruised mushrooms may appear less potent due to their color, their actual psilocybin levels may still be sufficient for the desired effect, especially if the bruising is minimal.
In summary, bruising impacts potency primarily through psilocybin degradation, but the extent of this effect depends on various factors. Safe consumption is not compromised by bruising, but users should be mindful of potential potency loss, especially in heavily damaged or improperly stored mushrooms. While visual changes are immediate and noticeable, they do not provide a complete picture of chemical degradation. To preserve potency, minimize bruising during handling and store mushrooms in optimal conditions, though some degree of bruising is inevitable and does not necessarily ruin the mushroom’s psychoactive properties.
Microwaving Mushrooms: Quick Tips for Perfectly Cooked Fungi
You may want to see also

Preventing or accelerating bruising (gentle handling, drying methods, environmental control, intentional pressure application)
Mushrooms, particularly those containing psilocybin, often exhibit a blue bruising reaction when their tissues are damaged. This occurs due to the oxidation of psilocin, a compound related to psilocybin. The time it takes for mushrooms to bruise blue can vary from a few minutes to several hours, depending on factors like the mushroom species, freshness, and environmental conditions. To manage this process—whether preventing or accelerating bruising—specific techniques can be employed, focusing on gentle handling, drying methods, environmental control, and intentional pressure application.
Gentle Handling is crucial for preventing bruising. Mushrooms are delicate, and rough handling can cause immediate tissue damage, leading to rapid blue discoloration. When harvesting or transporting mushrooms, use soft containers like baskets or trays lined with cloth. Avoid stacking them, as the weight can compress and damage the caps and stems. If cleaning mushrooms, gently brush off dirt instead of washing them, as moisture can accelerate bruising. For long-term storage, place mushrooms in a single layer on a breathable surface to minimize pressure points.
Drying Methods play a significant role in both preventing and accelerating bruising. To prevent bruising, air-dry mushrooms in a well-ventilated, shaded area. High heat or direct sunlight can stress the mushrooms, making them more prone to bruising. For faster drying, use a dehydrator set at a low temperature (around 40-50°C). If intentional bruising is desired, lightly mist the mushrooms with water before drying, as moisture can expedite the oxidation process. However, excessive moisture can lead to decay, so balance is key.
Environmental Control is essential for managing bruising. Mushrooms bruise more quickly in warm, humid conditions due to increased enzymatic activity. To prevent bruising, store mushrooms in a cool, dry place with temperatures between 2-4°C and humidity below 50%. For accelerating bruising, expose mushrooms to higher temperatures (20-25°C) and slightly elevated humidity (60-70%) for a controlled period. Ensure proper ventilation to avoid mold growth, which can ruin the mushrooms.
Intentional Pressure Application can be used to accelerate bruising for specific purposes, such as identifying psilocybin-containing species. Gently press the mushroom cap or stem with a blunt object, like a spoon or finger, to create localized damage. The affected area will turn blue within minutes to hours, depending on the mushroom’s freshness and environmental conditions. For uniform bruising, lightly squeeze the entire mushroom, but avoid crushing it, as this can release spores or damage the structure irreparably. This method is particularly useful for researchers or foragers verifying mushroom properties.
By mastering these techniques—gentle handling, appropriate drying methods, environmental control, and intentional pressure application—you can effectively manage the bruising process of mushrooms. Whether aiming to preserve their appearance or intentionally induce the blue reaction, understanding these factors ensures better control over the outcome. Always prioritize the mushroom’s integrity to maintain its quality and intended use.
Uncooked Shitake Mushrooms: Shelf Life and Freshness Tips
You may want to see also
Frequently asked questions
Mushrooms that naturally turn blue when bruised, such as Psilocybe species, typically show discoloration within seconds to a few minutes after being handled or damaged.
Yes, the speed of blue bruising can vary depending on the mushroom species and environmental factors, but most Psilocybe mushrooms bruise blue almost immediately upon contact.
Yes, factors like temperature, humidity, and the mushroom's freshness can influence how quickly or intensely the blue bruising appears, though the reaction is generally rapid.

























